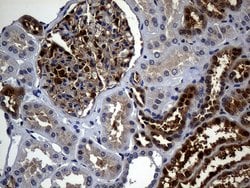
SULT1A3 Monoclonal Antibody (OTI3G5), TrueMAB , OriGene 30 &mu;L; Unconjugated:Antibodies,

Learn More
SULT1A3 Monoclonal Antibody (OTI3G5), TrueMAB™, OriGene
Mouse Monoclonal Antibody
Brand: Origene Technologies TA811313S

Description
SULT1A3 Monoclonal antibody specifically detects SULT1A3 in Human samples. It is validated for Immunohistochemistry (Paraffin), Western BlotSpecifications
| SULT1A3 | |
| Monoclonal | |
| 1 mg/mL | |
| PBS with 1% BSA, 50% glycerol and 0.02% sodium azide | |
| Q96IY1 | |
| Mouse | |
| Affinity chromatography | |
| RUO | |
| 25936 | |
| -20° C, Avoid Freeze/Thaw Cycles | |
| IgG1 |
| Immunohistochemistry (Paraffin), Western Blot | |
| OTI3G5 | |
| Unconjugated | |
| NSL1 | |
| aryl sulfotransferase 1A3/1A4; Catecholamine-sulfating phenol sulfotransferase; CSPS; dopamine-specific sulfotransferase; HAST; HAST3; Monoamine-sulfating phenol sulfotransferase; monoamine-sulfating phenosulfotransferase; M-PST; phenol sulfotransferase 1A5; placental estrogen sulfotransferase; ST1A3; ST1A3/ST1A4; ST1A4; ST1A5; STM; sulfokinase; sulfotransferase 1A3; Sulfotransferase 1A3/1A4; Sulfotransferase 1A4; sulfotransferase family 1A member 3; sulfotransferase family, cytosolic, 1A, phenol-preferring, member 3; Sulfotransferase, monoamine-preferring; SULT1A3; SULT1A4; thermolabile (monoamine, M form) phenol sulfotransferase; Thermolabile phenol sulfotransferase; TL-PST | |
| Full length human recombinant protein of human NSL1 produced in E.coli. | |
| 30 μL | |
| Primary | |
| Human | |
| Liquid |
The Fisher Scientific Encompass Program offers items which are not part of our distribution portfolio. These products typically do not have pictures or detailed descriptions. However, we are committed to improving your shopping experience. Please use the form below to provide feedback related to the content on this product.